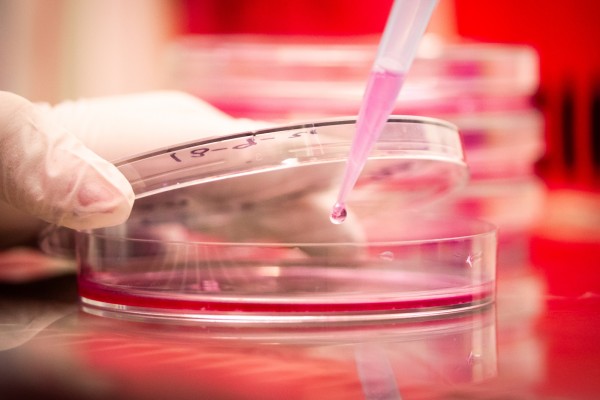

Abre convocatoria para el concurso nacional de fotografía científica
La Secretaría Nacional de Ciencia, Tecnología e Innovación (Senacyt) anunció el lanzamiento oficial de la séptima versión del Concurso Nacional de Fotografía Científica “FotoCiencia”.
El concurso va dirigido a fotógrafos panameños o extranjeros residentes, profesionales o aficionados a la fotografía animados a brindar una mirada propia relacionada con la investigación científica en Panamá.
Eduardo Ortega-Barría, secretario nacional de la Senacyt, señaló que “buscamos acercar el conocimiento científico a la población, y a través del concurso FotoCiencia estamos convencidos que mediante el arte se pueden transmitir sentimientos, compartir hechos y contar historias. Los exhortamos a que participen en esta iniciativa para así continuar aumentando el interés del público en la ciencia y la tecnología”.
Se detalló que en la categoría Investigación Científica: Las fotografías participantes deben ilustrar al menos uno de los siguientes elementos: El objeto de estudio de la actividad científica, es decir, el protagonista de la investigación. Las personas que se dedican a la ciencia realizando su labor.
Mientras que en la categoría Fotografía Microscópica: Las fotografías participantes deberán ilustrar el universo microscópico. Solo podrán participar fotos tomadas con microscopios y se deberá incluir en la descripción de la fotografía el equipo utilizado y la escala.
Por otro lado, para la categoría Niños y adolescentes en la Ciencia: Esta fotografía deberá reflejar la curiosidad de los niños y adolescentes por la ciencia, en los fenómenos relacionados con experimentos, observaciones que muestren quehacer científico, astronomía, robótica, tecnologías, naturaleza, entre otros.
Por último en la categoría Ambiente y Cambio Climático: Las fotografías participantes deberán ilustrar fotos que muestren estragos del cambio climático, contaminación o deforestación y que la ciencia pueda tener una alternativa para subsanarlo.
También podrían ser fotos de naturaleza, ecosistemas, manglares, playas, bosques, animales, plantas, lluvia, nubes, viento, entre otros, tomadas en la República de Panamá.
Los interesados en concursar podrán subir sus fotografías en la página web fotociencia.senacyt.gob.pa. La fecha de cierre del concurso “FotoCiencia” es el 10 de octubre de 2022, a las 3:00 p.m. (hora exacta).
Premios
Primer lugar de las Categorías de Investigación Científica; Fotografía Microscópica; Niños y adolescentes en la Ciencia; y Ambiente y Cambio Climático: B/. 1,000.00 cada uno.
Segundo lugar de las Categorías de Investigación Científica; Fotografía Microscópica; Niños y adolescentes en la Ciencia; y Ambiente y Cambio Climático B/. 500.00 cada uno.
Tercer lugar de las Categorías de Investigación Científica; Fotografía Microscópica; Niños y adolescentes en la Ciencia; y Ambiente y Cambio Climático: B/. 250.00 cada uno.
Los ganadores del Concurso serán anunciados en las redes sociales de la Senacyt: Instagram, Facebook y Twitter @senacyt. Participa en este concurso de manera gratuita.


